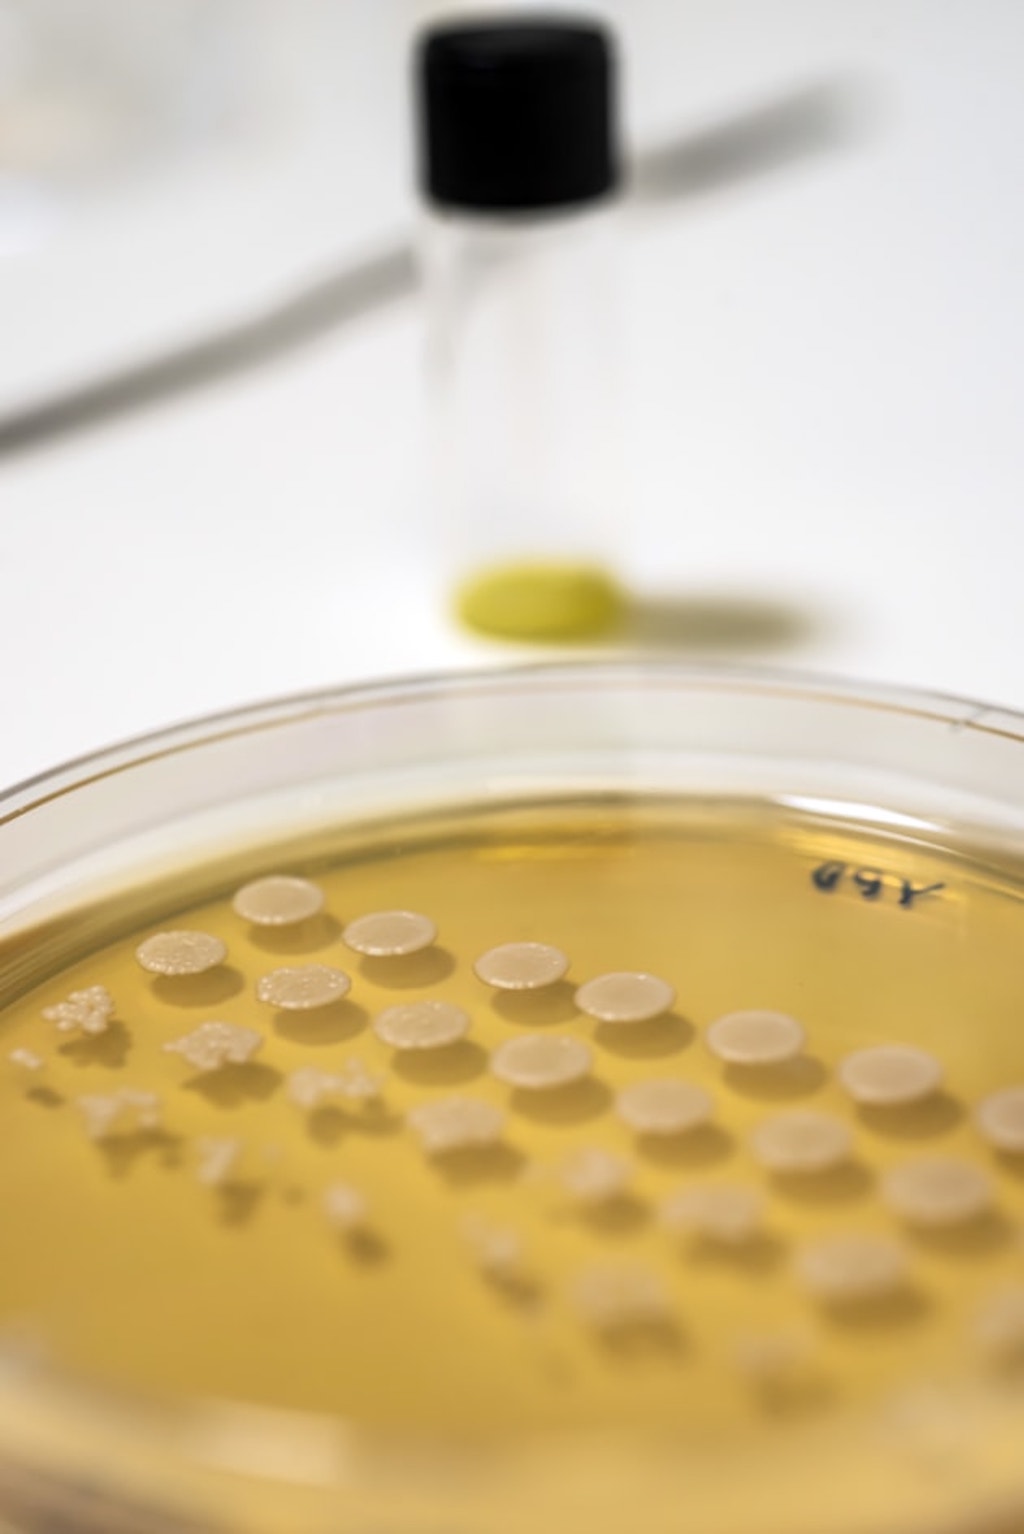

4 Mins Read
Consumers may soon be able to feast on alternative protein developed using both cellular agriculture and precision fermentation. In what is the first-ever partnership between a cell-based and precision fermentation startup, Aussie food techs Vow and Nourish Ingredients are teaming up to match cultured exotic meats with “brewed” animal-free fats to make a new hybrid alt-protein that is set to taste just as good, if not better, than real meat.
Some cell-based startups have debuted hybrid meat prototypes made from a blend of cell-cultured and plant-based ingredients. New Age Meats’ sausages and Higher Steaks’ pork belly, for instance, contain cultivated pork and plant-based proteins and fats. Other cell-based startups are dedicated to culturing fats, such as Mission Barns and Hoxton Farms, and they want products incorporated into vegan meat.

First-of-a-kind partnership in alternative protein
But there’s a new kind of hybrid alt-protein in town. It’s the first-ever collaboration between a cell-based startup and a precision fermentation food tech. Sydney-based Vow cultivates exotic meats like kangaroo and alpaca directly from these species’ cells, and Canberra’s Nourish Ingredients uses precision fermentation technology—the same tech that cow-free whey protein pioneer Perfect Day uses—to “brew” animal-free fats.
These two Aussie firms are now working together with the aim to develop hybrid meats that are going to be unbeatable in terms of taste. For Vow, plant-based fats like coconut oil don’t quite measure up to elevate its cell-cultured meats, which range from kangaroo to goat, rabbit, and lamb. That’s when the firm began searching for a new type of fat, and landed on Nourish.
“We’re obsessed with food, not purists on technology,” announced Vow co-founder and CCO Tim Noakesmith. “Nourish Ingredients share our vision that these tech breakthroughs are here to make newer, richer menu options, not replicate exactly what we already had, so we figured better to make it official and partner up.”

Nourish is one of the only startups in the rising precision fermentation space dedicated to “brewing” animal-free lipids, the other example being Sweden’s Melt&Marble. Setting out to help other alt-protein companies deliver on the sensorial texture and taste of its real meat counterparts, like the marbling on a cut of steak, or the elasticity of melted dairy cheese, Nourish uses the tech to customise sustainable, animal-free fats and oils.
Tailoring fat for cell-based meat
Breaking the news in a Forbes article, Noakesmith said that combining the two technologies will help create something that could actually outperform the standard real meat-eating experience. It’s in line with Vow’s original mission, which was to cultivate animal meat from not-so-well-known exotic species to offer a unique culinary experience, recently proving it in a tasting event with renowned Chef Neil Perry.
Commenting on the partnership, Nourish CEO and co-founder James Petrie told Forbes: “This partnership with Vow, who focus so relentlessly on the pursuit of the best eating experience possible, presents a win-win for consumers and the environment alike.”
Noakesmith added that the collaboration is a “bit like SpaceX meets Willy Wonka’s Chocolate factory,” with both companies “constantly running iterations, making incremental improvements and performing tests and analysis” to find the perfect custom-made animal-free fat tailored for Vow’s cell-based meats.
Both firms didn’t reveal the specific product that they’re working on, but disclosed that it’s not going to come in a typical mince, patty or meatball format. “We are working on something that has a more of a whole-muscle style texture, like a fillet,” shared Vow’s CCO.

Hybrid is the future
For some industry watchers, cross-pollination between different alt-protein tech pillars is only going to become more common. After seeing more partnerships between plant-based and cell-based firms, and even startups dedicated to a hybrid of the two (Moolec Science, for example), it was only a matter of time before precision fermentation players got in on the collaborative effort too.
Speaking to Green Queen Media about what he believes will shape the future of the industry, Future Food Now founder and alt-protein investor Michal Klar simply said: “My answer for now is probably hybrid.”
Petrie, now having become the first fermentation firm to forge a partnership with a cell-ag company, says it’s only “inevitable” that similar partnerships will “start to happen more often, across the industry.”
The two Australian food techs have been high on the watch-list for investors, having both closed successful rounds this year. In January, Vow bagged $6 million in seed funding from VCs like Square Peg and Blackbird, while Nourish secured $11 million in March in a round co-led by Hong Kong billionaire Li Ka-shing’s Horizons Ventures.
Lead image courtesy of Vow Food.




